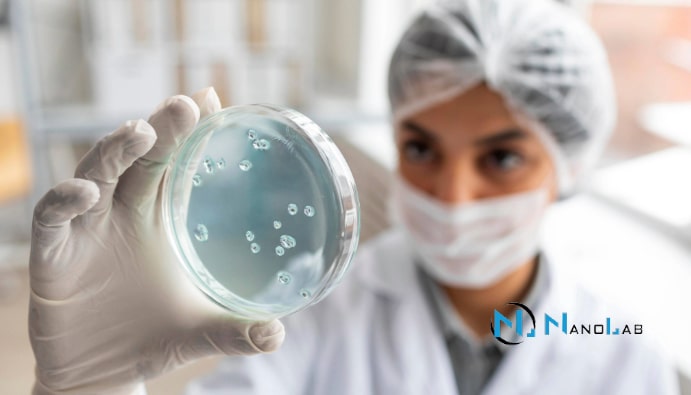

Жеміс шырындарындағы жеміс қатынасын анықтау АРЫ ҚАРАЙ ОҚУ

BLOG

Жеміс шырындарындағы жеміс қатынасын анықтау АРЫ ҚАРАЙ ОҚУ

Жеміс шырынының түпнұсқалығын талдау АРЫ ҚАРАЙ ОҚУ

Тамақ өнімдерін радиоактивтілікке талдау АРЫ ҚАРАЙ ОҚУ

Протеолитикалық бактерияларды анықтау АРЫ ҚАРАЙ ОҚУ
Липолитикалық бактерияларды анықтау АРЫ ҚАРАЙ ОҚУ

Сүттегі соматикалық жасуша санын анықтау АРЫ ҚАРАЙ ОҚУ